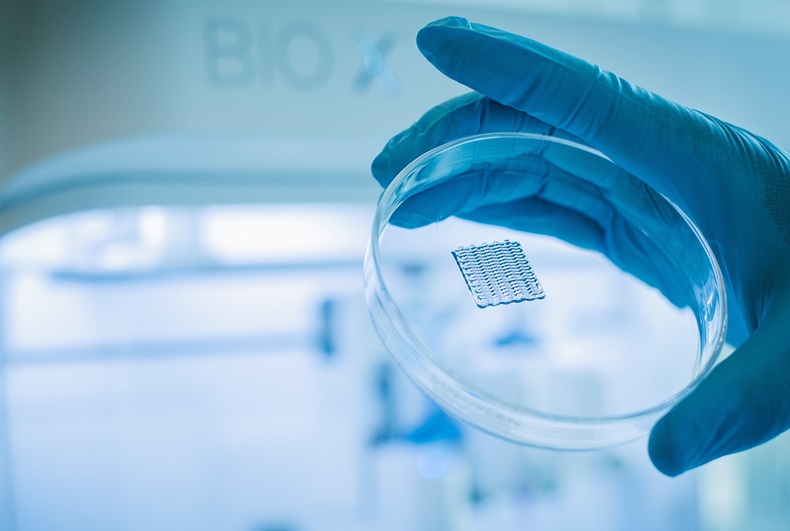

Bioimpresora 3D BIO X6™
6 cabezales de impresión que permiten estructuras más complejas y modelos fisiológicamente relevantes.
La tercera generación de la bioimpresora más avanzada, que permite el cultivo celular 3D de alto rendimiento y la biofabricación para crear el futuro de la salud.
Más Información
BIO X6 se adapta a cualquier configuración de laboratorio que desee. El intuitivo software integrado le permite trabajar desde la tableta incluida o desde un ordenador. Controle todos los aspectos de su impresión desde el intuitivo y fácil de usar software DNA Studio en su tableta o portátil. Ya sea impresión multicapa, entrecruzamiento capa por capa, definición de materiales personalizados o incluso almacenamiento de protocolos, el software BIO X6 lo tiene todo.
Documentación
Bioimpresora 3D BIO X6™
| Título | Información del Archivo |
|---|---|
| catalogo-bioimpresoras-3d-serie-bio-x-cellink-en.pdf | 1.88 MB |
| guia-rapida-bioimpresoras-3d-serie-bio-x-cellink-en.pdf | 266.65 KB |
| catalogo-bioimpresoras-3d-extrusion-luz-cellink-en.pdf | 4.41 MB |
| guia-rapida-bioimpresoras-3d-extrusion-luz-cellink-en.pdf | 2.14 MB |

Servicio Técnico Oficial
Formados por los propios fabricantes

Cobertura Nacional
Más de 70 técnicos especializados

Aplicaciones a Medida
Diseño y soporte adaptado a tu laboratorio

Formación a Usuarios
Capacitación para un manejo eficiente